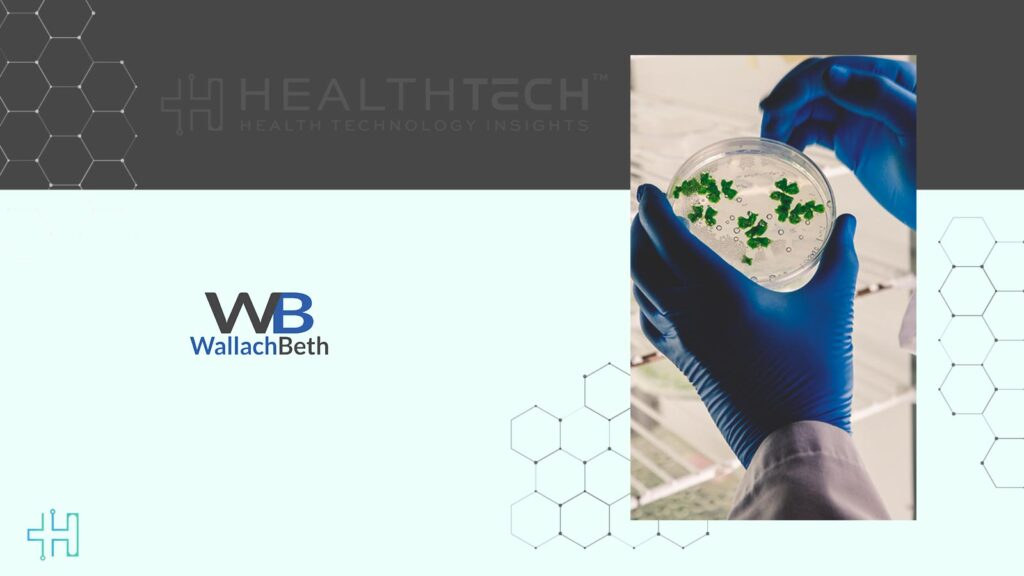

WallachBeth Capital LLC, a well-known firm that focuses on capital markets and institutional trading, shared that bioAffinity Technologies, Inc., a biotech company working on noninvasive early cancer detection tests, has finished its latest public offering. The company collected a total of $4.8 million before subtracting any fees or other costs.
Health Technology Insights: HYVE Labs and MindHYVE Unveil ChironAI Clinical System
The offering included selling 1,921,761 shares of common stock or, in another option, pre-funded warrants. Each share was sold for $2.50, while each pre-funded warrant was priced at $2.493. These warrants can be exercised right away to convert into one common stock share at a price of $0.007 per share. The price set for the warrants is just a little lower than the common stock price.
Health Technology Insights: NextGen, Kno2 Partner to Boost Health Data Sharing
WallachBeth Capital was the only placement agent involved in this deal. It’s important to remember that this announcement isn’t an offer to sell or a request to buy securities. In areas where such actions are not allowed without proper registration or qualification under securities laws, no sales will take place.
The securities were issued under an effective registration statement on Form S-1 (File No. 333-290480), which was filed with and approved by the Securities and Exchange Commission. This release should not be considered as an offer to buy or sell securities in any place where the offering isn’t allowed before it is properly registered or qualified. The offering is only available through a preliminary and final prospectus that’s part of the registration statement.
bioAffinity Technologies continues to work on its goal of offering new solutions for early cancer detection while following all regulatory rules and growing its financial resources.
Health Technology Insights: Corstasis and U.S. Heart Team Up to Enhance Heart Failure Care
To participate in our interviews, please write to our HealthTech Media Room at sudipto@intentamplify.com